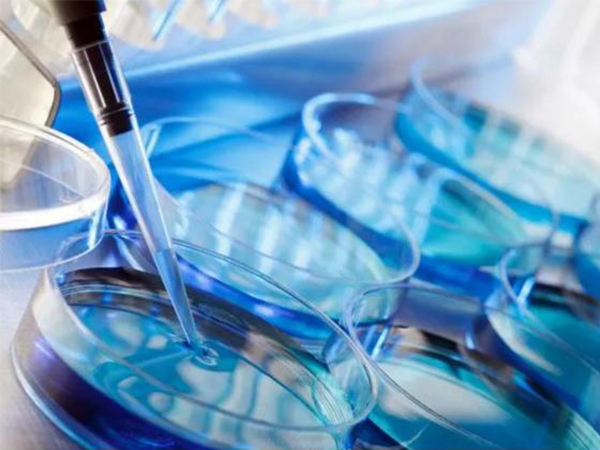
赴马试管要做好攻略

马来西亚是一个医旅国家,医疗环境很好,因此近年有很多的不孕不育家庭或者有特殊生育需求的家庭,奔赴去马来西亚做三代试管婴儿,因为人生地不熟的原因,所以建议在赴马试管前,一定要做好试管攻略,了解赴马试管的详细流程,避免走弯路。

马来西亚以医疗+旅游闻名
马来西亚是一个医疗+旅游一体的国家,因此每年有很多的国人前往马来西亚开展医疗服务。其中,有很多家庭是为了做试管婴儿,马来西亚是试管成功率领先的一个国家,技术和设备都十分先进,同时试管的价格也比较实惠,因此每年吸引了很多的不孕不育家庭。但同时,因为语言、环境等因素,很多人去马来西亚试管都会走一些弯路,因此在赴马之前,一定要做好攻略。
去马来西亚做试管前要做好相关流程攻略
细说马来西亚试管婴儿全流程
随着当地政府的大力支持,马来西亚逐渐成为了全球医疗保健旅游的重要目的地之一,在赴马来西亚做试管婴儿的流程不同于国内,因为毕竟是海外医疗,所以流程上相对麻烦一些。
除此之外医疗流程和国内医院,都会经历前期身体检查、定方案、促排卵、取卵取精、胚胎培养、胚胎移植、验孕等等,不进行鲜胚移植,两次往返马来西亚的详细行程如下:
初次赴马来西亚试管流程:
4月4日:来大姨妈来的头一天;
4月5日:飞马来西亚,中介安排接机;
4月6日:约见中介泰国公司负责人,见医生开始促排;
4月7日~5月15日:促排二天到十天,期间每隔2-3天测一次血值报告,见一次医生;
4月9日~5月12日:检测开始频繁,卵泡发育即将成熟;
4月16日:晚上10点打夜针;
4月18日:早上10点开始取卵;
4月20日:休息一天后回国;
4月23日:收取受精卵成五天囊胚报告。

取卵后建议多休息一天再回国
这是一对真实用户反馈的试管具体流程和具体时间,用户是通过中介前往的,因为是初次赴马没有经验,因此建议对马来西亚不熟悉的用户联系中介,如果没有地理、语言障碍的用户可以结合详细流程做好攻略前往。
二次赴马来西亚试管流程:
6月20日:大姨妈头一天;
6月31日:到达吉隆坡(大姨妈12天);
7月1日:见医生,验血值,按照医生的要求吃药塞药;
7月6日:中午移植两个囊胚;
7月13日:抽血验孕;
7月16日:验孕HCG值翻倍;
7月17日:回国,中介安排送机。
以上就是本次马来西亚试管婴儿的全部流程,初次取卵花费了大概15天时间,二次过来大概17天左右,停留马来西亚差不多32天。用户反映因为时间不干的原因并没有很着急,有意逗留了几天。

抽血化验确诊怀孕后就可以准备回国
赴马来西亚试管婴儿成功经验分享
除了上述的具体流程,还有一些赴马来西亚试管的成功经验分享,主要有5点:
1、要知道与一般旅游不同,医疗旅游多了医疗的安排,所以为了避免旅途奔波劳累,就需要将旅程安排得更轻松悠闲一些,建议找一个中介提前商讨好出行计划;
2、再有就是在过来前,一定要综合考量选择马来西亚试管婴儿医院、医生。医院的名气很重要,需要有针对性地进行医疗信息搜集,包括医院成立时间、下设科室、医生实力,医院认证与荣誉能一定程度上代表实力,而医生团队实力可通过其发表过的文献来考量;
3、提前准备完备资料,原病例、影像资料要准备好,建议在出国就医前就通过扫描或邮件给相关医生看,更利于医生提前掌握病情,做到心中有数;
4、有语言交流问题的国家应寻求陪同翻译,如果是找了中介这些就不需要操心了,本身医疗是相对专业的领域,看病时的陪同翻译利于与医生进行沟通,能免除语言沟通障碍的国家更适合与医生交流,更方便;
5、签证有足够看病的逗留时间,若是需要逗留的时间超过签证允许时间,应提前办理延期手续,避免出现逾期逗留的问题。
总之去马来西亚做试管婴儿不是一件小事情,一定请提前做好攻略,多了解下当地的医院、费用、成功率和流程等等,做好出行心中有数,好孕才会更快到来。
本文由嘉胜国际整理发布,禁止抄袭、复制、转载或引用











